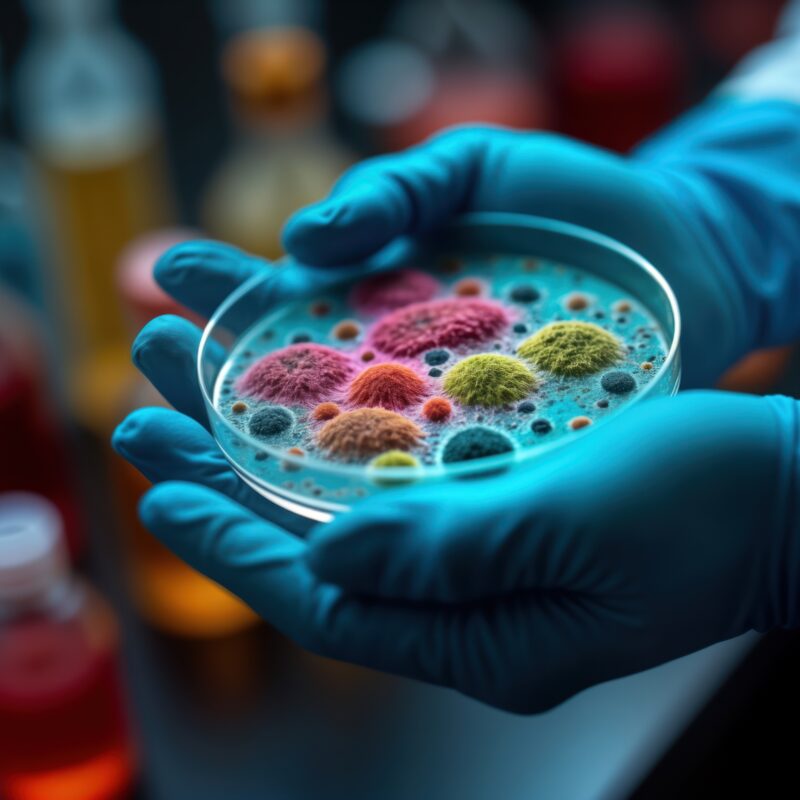

Recent Posts
- Daily Dispatch — COP30, Belém — 22 November 2025 — The Gavel Fell, the Drama Didn’t
- Daily Dispatch — COP30, Belém — 21 November 2025 — So Much for “The Final Day”
- Daily Dispatch — COP30, Belém — 20 November 2025
- Turkey Hosts, Australia Chairs: COP31’s Odd-Couple Climate Summit
- Daily Dispatch – COP30, Belém – 19 November 2025
Recent Comments
No comments to show.